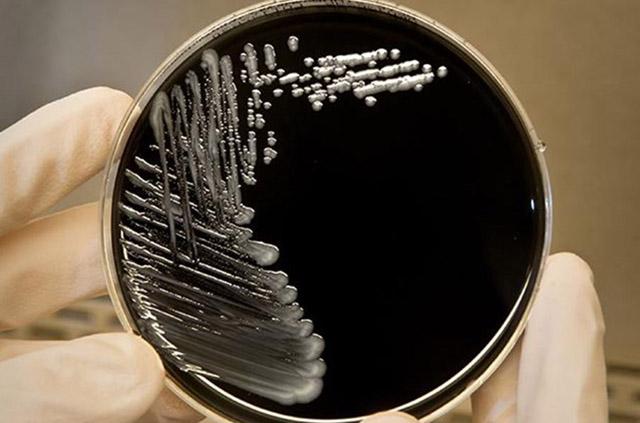
Media Name: legionella_2_test_crop_.jpg

Case of Legionella pneumonia identified
UW Medicine is working closely with Public Health–Seattle & King County and the Washington State Department of Health to investigate the case.Media Contact: Susan Gregg, UW Medicine, 206-390-3226, sghanson@uw.edu
A patient treated in September at UW Medical Center-Montlake was diagnosed with Legionella pneumonia presumed to be a healthcare-associated infection. The diagnosis was made after the patient was transferred to another facility for further care. This is believed to be an isolated case and no additional cases of Legionella have been identified at UW Medical Center - Montlake at this time. We are working closely with Public Health – Seattle & King County and the Washington State Department of Health to investigate this case and to ensure the safety of patients and staff.
UW Medical Center has a robust water management plan that includes testing and monitoring of water temperature, chlorine levels and the presence of water-borne bacteria.
“We don’t know the source of the patient’s infection in this particular case, and we may never know the source,” said Dr. Matt Hanson, deputy chief for the Public Health–Seattle & King County Communicable Disease Program. “However, a case of Legionnaires’ disease with 10 or more days of continuous stay at a healthcare facility during 14 days before onset of symptoms is considered a presumptive Legionnaires’ disease healthcare- associated infection. We are working closely with UW Medical Center on this case investigation and they have a robust Legionella prevention and response plan in place and are taking all recommended steps.
“Legionella is a common water-borne bacteria and most healthy people exposed to Legionella do not get sick. People at increased risk of getting sick include cigarette smokers and people with certain underlying health conditions including chronic lung disease or weakened immune systems", Hanson said.
For details about UW Medicine, please see our About page.